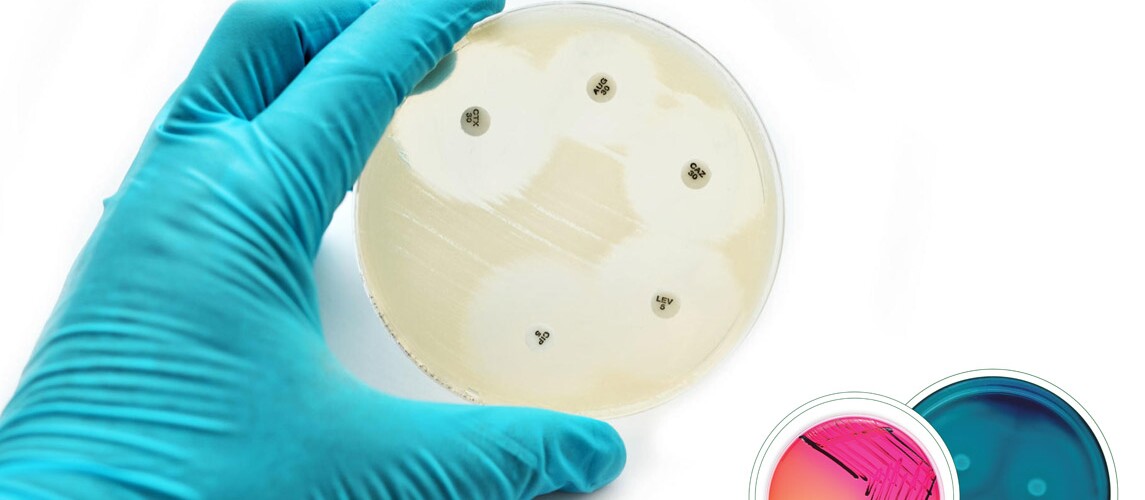

Wyszukaj
Zmień rozmiar czcionki
Wersje kontrastowe
Lubuski Wojewódzki Lekarz Weterynarii
Lubuska Izba Lekarsko - Weterynaryjna
Instytut Nauk Biologicznych UZ
zapraszają na wykłady:
prof. dr hab. Dariusza Wasyla
PIW-PIB Puławy
“Salmonelloza - problem czy wyzwanie”
“Monitoring oporności na antybiotyki - co mówią bakterie”
26 listopada 2025
godzina 11.00 -13.00
Uniwersytet Zielonogórski, Instytut Nauk Biologicznych,
ul. Profesora Szafrana 1, budynek A8, sala 115



